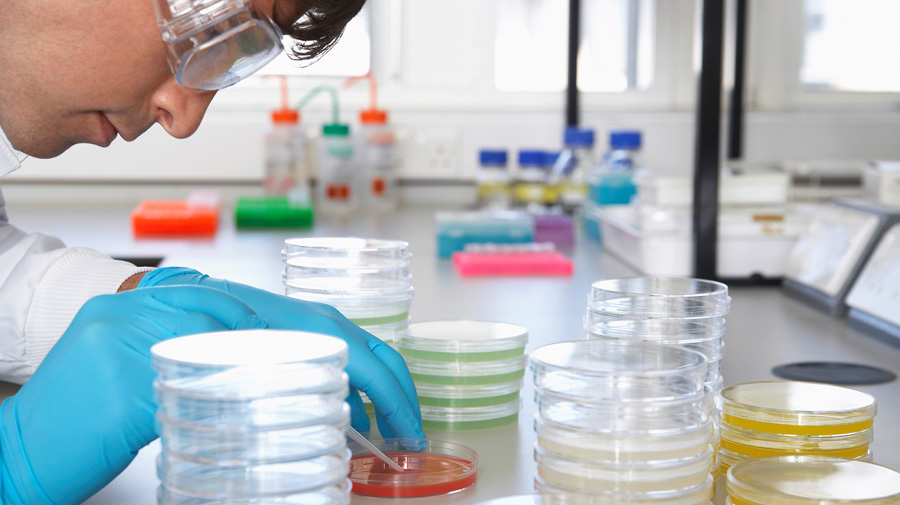
BlueThunderTech's tweet image. Unseen Sources of Contamination in the Cleanroom: zcu.io/zk6r 

#contaminationcontrol #cleanroom #controlledenvironments #cleanroomsupplies #bluethundertechnologies
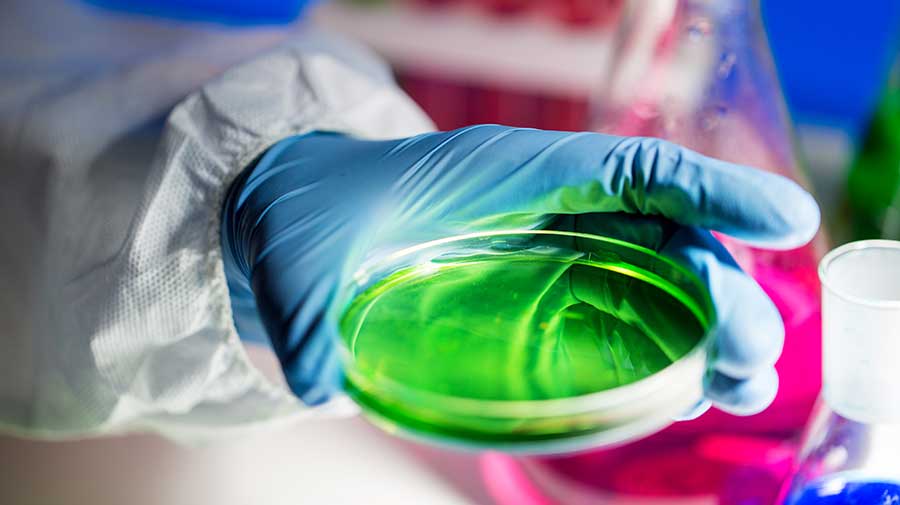
BlueThunderTech's tweet image. The Importance of Global Standardization for Cleanroom Industry: bluethundertechnologies.com/the-importance…
.
.
#controlledenvironments #contaminationcontrol #cleanroom #standards

#controlledenvironments arama sonuçları
Your reputation depends on the quality and consistency of your product. Shifts in the production environment can mean shifts to both. Which is why we help companies build and maintain #ControlledEnvironments. See us at #IPPE2020, the world’s largest production & processing expo

Stay up to date with what we're up to by signing up to our monthly newsletter! 👉Subscribe here: ow.ly/m3yW50WUtlG #agritech #agribusiness #controlledenvironments #roboticsandautomation #advancedsensors #AIanddatasystems #engineeringbiology



botanical_: Using @arduino-based microcontrollers and sensors to build an inexpensive CO2 control system for growth chambers bsapubs.onlinelibrary.wiley.com/doi/full/10.10… @wileyplantsci @um_research @TheresaCulley @gypsumbotany #iamabotanist #controlledenvironments

@TheGFIA Day 2 underway @BCEC_Brisbane in the #ControlledEnvironments&ProtectedCropping Theatre with @QldFarmers Andrew Chamberlin talking #EnergySavers programme - check out the battery-powered @JohnDeere tractor !


We’re redefining how cucumbers are grown — #vertically, #sustainably, and locally. 🥒 Urban farms use 90% less water and minimum pesticides to deliver fresh cucumbers year-round. Grown in #controlledenvironments for consistent quality.

Stay up to date with all things agri-tech by signing up to our monthly newsletter! 👉Subscribe here: ow.ly/m3yW50WUtlG #agritech #agribusiness #controlledenvironments #roboticsandautomation #advancedsensors #AIanddatasystems #engineeringbiology

The frustration watching these scenes & the disparity of how @gardainfo treat this situation vs business owners. I had Gardai counting people on my terrace when it was 15 outdoors. How will businesses be treated on reopening? #controlledenvironments @RAI_ie @adriancummins
When it comes to maintaining a controlled environment, having the proper cleanroom supplies on hand is critical. Download our free cleanroom cleaning process guide today to dig deeper: lnkd.in/exfrW9jf #controlledenvironments #cleanrooms
CE Colleague of the month is awarded to Melanie Topping. After receiving client feedback for always going above and beyond. Mel was awarded £25 shopping voucher. Well done Mel, & thank you. @BidvestNoonan #rewardandrecognition #controlledenvironments

Well done Dianne - Employee of the month @bidvestnoonan #Manufacturing #controlledenvironments #rewardandrecognition

A huge well done to Helen Harper @BidvestNoonan keeping the standards exemplary #manufacturing #pharma #controlledenvironments

🌸 Editor’s Choice Articles 🌱 Effects of Daily Light Integral on Compact #Tomato Plants Grown for Indoor Gardening by Stephanie Cruz and Celina Gómez 👉 Read here: doi.org/10.3390/agrono… #controlledenvironments #DLI #indoorfarming #LEDs #urbanagriculture #vegetablegarden

Great days at the Controlled Environment Users Group (CEUG) Meeting at Aberystwyth University 🇬🇧 with our partners from @AlphatechUK! #plantresearch #plantsciences #controlledenvironments #biotechnology #aralab #yourownclimate ⚫️🟢🔵🔴



recreating #alteredlandscapes in #controlledenvironments. #gursky at the #haywoodgallery reopening, london 2018. image: @monotyper #instagram

🧪 Purity. Precision. Performance. In sectors where contamination is not an option, Grupo Suntak delivers controlled environments engineered to meet the most rigorous standards. #CleanRooms #PrecisionEngineering #ControlledEnvironments #SmartConstruction #IndustrialSolutions
We're hiring! Join our team of researchers and academics as a faculty member leading research on Controlled Environments in horticultural science! Learn more and apply at z.umn.edu/hortfacultysea… #higheredjobs #controlledenvironments

Cleanrooms and controlled environments have similar capabilities but differ in key features. Read our blog to discover their differences and find which suits your application. Read now: bit.ly/3Pr6iY6 #Cleanrooms #ControlledEnvironments #AirInnovations

Stay on top of your facility's #ISO standards with the Thomas Scientific #ControlledEnvironments & Safety portfolio. Offering products from 250+ top suppliers to help you maintain a safe and clean workplace! Shop now at ow.ly/ovFF50ISuLi #labsupplies #labneeds
Protect your cleanrooms & controlled environments! Discover how to ensure multi-hazard protection with expert insights. ✅ Perfect for designers & engineers. 👉 Read more: bit.ly/41VYCVK #CleanroomDesign #SafetyFirst #ControlledEnvironments #EngineeringSolutions
Join us in announcing our #ControlledEnvironments and #Cleanroom Solutions Specialists on Thursday. We have a team of controlled environment experts dedicated to providing you with products and service solutions for all your manufacturing requirements. ow.ly/l8Xp50Gu6h9

Stay up to date with what we're up to by signing up to our monthly newsletter! 👉Subscribe here: ow.ly/m3yW50WUtlG #agritech #agribusiness #controlledenvironments #roboticsandautomation #advancedsensors #AIanddatasystems #engineeringbiology



Stay up to date with what we're up to by signing up to our monthly newsletter! 👉Subscribe here: ow.ly/m3yW50WUtlG #agritech #agribusiness #controlledenvironments #roboticsandautomation #advancedsensors #AIanddatasystems #engineeringbiology



Stay up to date with what we're up to by signing up to our monthly newsletter! 👉Subscribe here: ow.ly/m3yW50WUtlG #agritech #agribusiness #controlledenvironments #roboticsandautomation #advancedsensors #AIanddatasystems #engineeringbiology



Stay up to date with all things agri-tech by signing up to our monthly newsletter! 👉Subscribe here: ow.ly/m3yW50WUtlG #agritech #agribusiness #controlledenvironments #roboticsandautomation #advancedsensors #AIanddatasystems #engineeringbiology

Stay up to date with all things agri-tech by signing up to our monthly newsletter! 👉Subscribe here: ow.ly/m3yW50WUtlG #agritech #agribusiness #controlledenvironments #roboticsandautomation #advancedsensors #AIanddatasystems #engineeringbiology

💡 Knowledge of negative and positive air chambers is vital in healthcare facility restoration. Explore how these chambers ensure safety and maintain controlled environments for better patient care. #HealthcareRestoration #ControlledEnvironments #ChooseCRC hubs.li/Q03y5Zq40
In controlled environments, compliance is critical. ESP delivers service aligned with strict protocols—through highly trained teams, consistent execution, regulatory compliance and a proactive approach that helps support audit readiness. #ControlledEnvironments #ESPTeam

🧪 Purity. Precision. Performance. In sectors where contamination is not an option, Grupo Suntak delivers controlled environments engineered to meet the most rigorous standards. #CleanRooms #PrecisionEngineering #ControlledEnvironments #SmartConstruction #IndustrialSolutions
"In BIOT, livestock farming would likely be confined to small, controlled environments, such as pens or barns, to prevent overgrazing and maintain ecological balance. #ControlledEnvironments #SmallScaleFarming #EcologicalBalance
In biotech environments, compliance matters. ESP Facility Services helps maintain high-performance controlled environment space through compliance that reduces risk and keeps your operations running smoothly. #ControlledEnvironments #ProactiveSolutions #BiotechSupport

We’re redefining how cucumbers are grown — #vertically, #sustainably, and locally. 🥒 Urban farms use 90% less water and minimum pesticides to deliver fresh cucumbers year-round. Grown in #controlledenvironments for consistent quality.

At URS Labs, we ensure your healthcare environments meet the highest standards of sterility and compliance. urslabs.com #CleanRoomValidation #ControlledEnvironments #EnvironmentalCompliance #Pharmaceuticals #DataCenters #HospitalStandards #CleanRoomServices #URSLabs

20. The potential for future agricultural growth in Antarctica lies in the continued development of controlled environments that support crop production in extreme conditions. #ControlledEnvironments #FutureAgriculture
💡 Knowledge of negative and positive air chambers is vital in healthcare facility restoration. Explore how these chambers ensure safety and maintain controlled environments for better patient care. #HealthcareRestoration #ControlledEnvironments #ChooseCRC hubs.li/Q02yDxNk0
botanical_: Using @arduino-based microcontrollers and sensors to build an inexpensive CO2 control system for growth chambers bsapubs.onlinelibrary.wiley.com/doi/full/10.10… @wileyplantsci @um_research @TheresaCulley @gypsumbotany #iamabotanist #controlledenvironments

Your reputation depends on the quality and consistency of your product. Shifts in the production environment can mean shifts to both. Which is why we help companies build and maintain #ControlledEnvironments. See us at #IPPE2020, the world’s largest production & processing expo

We’re redefining how cucumbers are grown — #vertically, #sustainably, and locally. 🥒 Urban farms use 90% less water and minimum pesticides to deliver fresh cucumbers year-round. Grown in #controlledenvironments for consistent quality.

Stay up to date with what we're up to by signing up to our monthly newsletter! 👉Subscribe here: ow.ly/m3yW50WUtlG #agritech #agribusiness #controlledenvironments #roboticsandautomation #advancedsensors #AIanddatasystems #engineeringbiology



Stay up to date with all things agri-tech by signing up to our monthly newsletter! 👉Subscribe here: ow.ly/m3yW50WUtlG #agritech #agribusiness #controlledenvironments #roboticsandautomation #advancedsensors #AIanddatasystems #engineeringbiology

Stainless Steel in Cleanrooms – What You Need to Know: ow.ly/h1Oo30lWIkb ... #cleanroom #controlledenvironments #contaminationcontrol #sterile #stainlesssteel

Using @Arduino-based microcontrollers and sensors to build an inexpensive CO2 control system for growth chambers bsapubs.onlinelibrary.wiley.com/doi/full/10.10… @wileyplantsci @um_research @TheresaCulley @gypsumbotany #iamabotanist #controlledenvironments

Well done Dianne - Employee of the month @bidvestnoonan #Manufacturing #controlledenvironments #rewardandrecognition

Advertise with ASHS! ASHS Annual Conference Exhibitor Early Bird pricing deadline is January 15th. Online publication page ads available. More information at ashs.org/page/Advertisi… #horticulture #plantscience #controlledenvironments #LED #verticalfarming #agtech

🌸 Editor’s Choice Articles 🌱 Effects of Daily Light Integral on Compact #Tomato Plants Grown for Indoor Gardening by Stephanie Cruz and Celina Gómez 👉 Read here: doi.org/10.3390/agrono… #controlledenvironments #DLI #indoorfarming #LEDs #urbanagriculture #vegetablegarden

A huge well done to Helen Harper @BidvestNoonan keeping the standards exemplary #manufacturing #pharma #controlledenvironments

@TheGFIA Day 2 underway @BCEC_Brisbane in the #ControlledEnvironments&ProtectedCropping Theatre with @QldFarmers Andrew Chamberlin talking #EnergySavers programme - check out the battery-powered @JohnDeere tractor !


Surprising Ways Industries Are Using Clean Rooms: bluethundertechnologies.com/surprising-way… #cleanrooms #controlledenvironments #cleanroomindustry #contaminationcontrol #clean #manufacturing

Cleanrooms and controlled environments have similar capabilities but differ in key features. Read our blog to discover their differences and find which suits your application. Read now: bit.ly/3Pr6iY6 #Cleanrooms #ControlledEnvironments #AirInnovations

Qinglu Ying will defend her PhD Thesis August 25, 1pm. Qinglu was supervised by our own Prof. Youbin Zheng. She researched #LED light spectra to improve the quality of #microgreens. Details: ses.uoguelph.ca/events/2020/08… #ControlledEnvironments #UofG

PACE Systems, CCC's new joint venture with Puga Thermal Services, debuted at the 44th CEBA Conference and Expo! Surrounded by industry professionals to learn more about controlled environment construction, design, and maintenance. #CCC #PACESystems #ControlledEnvironments

Great days at the Controlled Environment Users Group (CEUG) Meeting at Aberystwyth University 🇬🇧 with our partners from @AlphatechUK! #plantresearch #plantsciences #controlledenvironments #biotechnology #aralab #yourownclimate ⚫️🟢🔵🔴



We're hiring! Join our team of researchers and academics as a faculty member leading research on Controlled Environments in horticultural science! Learn more and apply at z.umn.edu/hortfacultysea… #higheredjobs #controlledenvironments

Unseen Sources of Contamination in the Cleanroom: zcu.io/zk6r #contaminationcontrol #cleanroom #controlledenvironments #cleanroomsupplies #bluethundertechnologies
The Importance of Global Standardization for Cleanroom Industry: bluethundertechnologies.com/the-importance… . . #controlledenvironments #contaminationcontrol #cleanroom #standards
Something went wrong.
Something went wrong.
United States Trends
- 1. Texas A&M 14.5K posts
- 2. Arch Manning 4,659 posts
- 3. Marcel Reed 3,380 posts
- 4. Aggies 6,743 posts
- 5. Sark 3,120 posts
- 6. #SmackDown 14.9K posts
- 7. #iufb 2,880 posts
- 8. #BedBathandBeyondisBack 1,508 posts
- 9. #OPLive 2,012 posts
- 10. SEC Championship 3,016 posts
- 11. Georgia 45.3K posts
- 12. Eagles 142K posts
- 13. Bears 129K posts
- 14. Jeff Sims N/A
- 15. Elko 1,562 posts
- 16. Purdue 6,025 posts
- 17. Lindor 2,068 posts
- 18. Brunson 5,844 posts
- 19. Wingo 1,832 posts
- 20. Ben Johnson 28.2K posts



























